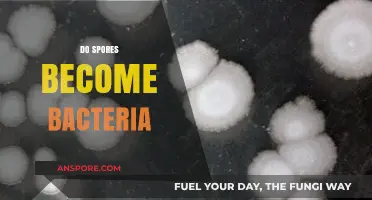
Do Spores Transform into Bacteria? Unraveling the Microbial Mystery

When considering the use of spore syringes, a common question arises: do they come with needles? Spore syringes, primarily used in mycology for the cultivation of mushrooms, typically contain a sterile solution with mushroom spores suspended in it. However, they are generally sold without needles, as the intended application often involves injecting the spore solution into a substrate using a separate, sterile syringe and needle. This separation ensures that users can choose the appropriate needle size and maintain proper sterilization practices. Therefore, if you’re purchasing a spore syringe, you’ll likely need to acquire a compatible needle separately.
| Characteristics | Values |
|---|---|
| Do spore syringes come with needles? | Typically, no. Spore syringes usually do not include needles. |
| Purpose of spore syringes | Used for mushroom cultivation to inoculate substrates with spores. |
| Contents of a spore syringe | Sterile syringe filled with spore solution and sometimes a Luer lock tip. |
| Needles required | Yes, but not included. Users must purchase needles separately. |
| Recommended needle type | 18-20 gauge sterile needles with Luer lock compatibility. |
| Reason for separate needles | Ensures sterility and allows users to choose appropriate needle size. |
| Availability of kits | Some vendors offer spore syringe kits that include needles. |
| Legal considerations | Check local laws regarding spore syringes and cultivation tools. |
| Storage of spore syringes | Store in a cool, dark place to maintain viability. |
| Usage instructions | Follow sterile techniques to avoid contamination during inoculation. |
Explore related products
What You'll Learn

What’s Included in a Spore Syringe Kit?
Spore syringes are essential tools for mycologists and hobbyists looking to cultivate mushrooms, but their contents can vary widely depending on the supplier. A typical spore syringe kit is designed to provide everything needed for the initial stages of mushroom cultivation, though not all kits are created equal. Understanding what’s included ensures you’re prepared for the process ahead.
Core Components: The Essentials
At the heart of every spore syringe kit is the spore syringe itself, a sterile syringe filled with a suspension of mushroom spores in distilled water. This is the primary tool for inoculating substrate, the material on which mushrooms grow. Most kits also include a sterile needle, though this isn’t always guaranteed. If a needle is provided, it’s typically a 16- or 18-gauge size, suitable for piercing injection ports on grow bags or jars. Always verify whether a needle is included, as some suppliers sell them separately for legal or logistical reasons.
Additional Tools: Beyond the Basics
Beyond the syringe and needle, many kits include alcohol wipes for sterilizing surfaces and tools before use. This is critical to prevent contamination, which can ruin an entire grow. Some kits also provide a spore storage vial, allowing you to preserve excess spores for future use. For beginners, instructional guides or access to online resources may be included, offering step-by-step directions for inoculation and cultivation. These extras can significantly enhance the user experience, especially for those new to mycology.
Variations and Customization
Not all spore syringe kits are standardized. Some suppliers offer customizable options, such as multiple spore strains in a single kit or additional syringes for larger projects. Others may include specialized tools like gloves, scalpel blades, or even pre-sterilized substrate bags. When selecting a kit, consider your skill level and the scale of your project. Advanced growers might opt for minimal kits, while beginners may benefit from more comprehensive packages.
Legal and Safety Considerations
It’s crucial to note that while spore syringes are legal in many regions for research and identification purposes, their use for cultivation may be restricted. Always check local laws before purchasing or using a spore syringe kit. Additionally, proper handling is essential to avoid contamination and ensure safety. Store spores in a cool, dark place, and dispose of used needles responsibly. Following these guidelines not only protects you but also ensures the integrity of your grow.
In summary, a spore syringe kit typically includes a spore-filled syringe, a needle (though not always), and sterilization tools. Additional components like storage vials or instructional materials may be included, depending on the supplier. By understanding what’s in the kit and how to use it, you can set the stage for a successful and rewarding mushroom cultivation experience.
Exploring the Microscopic World: What Do Spores Really Look Like?
You may want to see also

Do Spore Syringes Require Separate Needle Purchase?
Spore syringes, essential tools for mycology enthusiasts, often leave buyers wondering about their completeness. A common question arises: do these syringes come with needles, or is a separate purchase necessary? The answer varies by vendor and product type. Many spore syringes are sold as kits, including a needle, but some suppliers offer them à la carte, requiring you to buy the needle separately. This distinction hinges on the intended use—whether for research, education, or legal cultivation—and the seller’s packaging strategy. Always verify the product description to avoid inconvenience.
Analyzing the market reveals a trend: budget-friendly options often exclude needles to keep costs low, while premium kits bundle them for convenience. For instance, a standard 10ml spore syringe might cost $20 without a needle, whereas a kit with a sterile, 16-gauge needle could run $25. If you’re new to mycology, opting for a bundled kit saves time and ensures compatibility. However, experienced users might prefer purchasing needles separately to stock up on specific sizes or types, such as 18-gauge for thicker solutions.
From a practical standpoint, buying a needle separately isn’t complicated but requires attention to detail. Ensure the needle gauge matches the syringe’s Luer lock or slip tip for a secure fit. Sterility is non-negotiable; always choose individually wrapped, sterile needles to prevent contamination. If you’re working with multiple syringes, consider bulk needle purchases to reduce costs. Pro tip: store extra needles in a clean, dry container to maintain their integrity until needed.
Persuasively, opting for a bundled kit offers peace of mind, especially for beginners. It eliminates the risk of mismatching components and ensures everything is sterile and ready for use. However, if you’re cost-conscious or already have needles, purchasing à la carte makes sense. Just remember: the goal is to maintain a sterile environment, so never reuse needles or compromise on quality. Whether bundled or separate, the right choice depends on your needs and experience level.
Why You Can't Plant Gel Sack Spores: Common Mistakes and Solutions
You may want to see also

Types of Needles Compatible with Spore Syringes
Spore syringes, essential tools for mycologists and hobbyists cultivating mushrooms, often require compatible needles for precise inoculation. While some kits include needles, others do not, leaving users to source them separately. The type of needle used significantly impacts the success of the inoculation process, making compatibility a critical consideration.
Analytical Perspective:
Needles compatible with spore syringes typically fall into two categories: 16-gauge and 18-gauge. The 16-gauge needle, wider in diameter, is ideal for thicker substrates like wood chips or sawdust, as it allows for easier passage of spore solution. Conversely, the 18-gauge needle, narrower and more precise, is better suited for delicate substrates such as agar or grain spawn. The choice depends on the substrate’s density and the user’s need for accuracy. For instance, a 16-gauge needle might clog when used with fine-grained substrates, while an 18-gauge needle could struggle with denser materials.
Instructive Approach:
To ensure compatibility, follow these steps: First, verify the syringe’s Luer lock or slip tip, as this determines the needle attachment type. Luer lock needles provide a secure, screw-on fit, reducing the risk of leakage during inoculation. Second, sterilize the needle before use to prevent contamination. This can be done by flaming the needle with a lighter or alcohol lamp for 10–15 seconds. Finally, attach the needle firmly but gently to avoid damaging the syringe’s tip. For beginners, starting with an 18-gauge needle is recommended, as it offers versatility across various substrates.
Comparative Analysis:
While 16-gauge and 18-gauge needles dominate the market, specialized options like 20-gauge needles exist for ultra-fine inoculations, such as working with liquid cultures. However, these are less common and may not be necessary for standard mushroom cultivation. The key difference lies in flow rate: 16-gauge needles allow for faster dispersion, ideal for large-scale projects, while 18-gauge needles provide controlled, precise delivery, better for small or intricate setups. Cost-wise, 18-gauge needles are often more affordable, making them a practical choice for hobbyists.
Practical Tips:
Always keep spare needles on hand, as they can dull or break during use. Store them in a sterile container to maintain cleanliness. For those using multiple substrates, consider investing in a variety pack containing both 16-gauge and 18-gauge needles. When inoculating, apply gentle, steady pressure to avoid air bubbles, which can disrupt spore distribution. Lastly, dispose of used needles safely in a sharps container to prevent injury and contamination.
By understanding the types of needles compatible with spore syringes and their specific applications, users can optimize their cultivation process, ensuring successful and efficient inoculation every time.
Understanding Spores: Are They Haploid (n) or Diploid (2n)?
You may want to see also
Explore related products

How to Use a Spore Syringe Without a Needle
Spore syringes often come without needles, leaving users to source them separately or find alternative methods for application. This separation is primarily due to legal and logistical reasons, as including needles could complicate shipping and regulatory compliance. However, the absence of a needle doesn’t render the syringe useless; it simply shifts the focus to needle-free techniques. For those cultivating mushrooms or conducting mycological research, understanding how to use a spore syringe without a needle is essential for precision and safety.
One effective method involves using a sterile syringe to transfer the spore solution into a grow medium directly. Start by sterilizing your workspace and equipment with isopropyl alcohol to prevent contamination. Remove the cap from the spore syringe and attach a sterile Luer lock adapter, which allows you to connect the syringe to a sterile tubing system. Gently depress the plunger to expel a small amount of the spore solution into the tubing, ensuring it’s free-flowing. Then, carefully insert the tubing into a pre-sterilized substrate jar or grow bag, releasing the spores evenly across the surface of the medium. This method minimizes the risk of contamination while maintaining control over spore distribution.
Another approach is the "pour and shake" technique, ideal for liquid cultures or larger substrates. After sterilizing your workspace, remove the cap from the spore syringe and pour the contents into a sterile container. Mix the spore solution with a small amount of distilled water or nutrient broth to dilute it slightly, enhancing dispersal. Transfer the diluted solution into your grow medium, seal the container, and gently agitate it to distribute the spores evenly. This method is less precise than direct injection but works well for bulk substrates or when uniformity isn’t critical.
For those working with agar plates, a needle-free approach involves using a sterile scalpel or inoculation loop. Extract a small drop of spore solution from the syringe onto a sterile surface. Dip the scalpel or loop into the drop and streak it across the agar surface in a zigzag pattern. Incubate the plate in a controlled environment, allowing the spores to germinate and colonize the agar. This technique is commonly used in laboratory settings for isolating mushroom strains or studying mycelial growth.
Regardless of the method chosen, maintaining sterility is paramount. Always work in a clean environment, use gloves, and flame-sterilize tools when necessary. While spore syringes may not come with needles, their utility extends far beyond traditional injection methods. By mastering these needle-free techniques, cultivators can achieve successful results while adhering to safety and legal standards.
Spore Tribal Dynamics: How Parts Influence Gameplay and Strategy
You may want to see also

Safety Tips for Handling Spore Syringes and Needles
Spore syringes, often used in mycology for research and cultivation, typically do not come with needles. This separation requires users to source needles independently, emphasizing the need for careful handling to ensure safety and sterility. Whether you’re a novice or experienced, understanding how to manage these tools is critical to prevent contamination and injury.
Selection and Sterilization: Choose needles compatible with your spore syringe’s Luer lock or slip tip, typically 18–22 gauge for precision. Sterilize needles using an autoclave or isopropyl alcohol (70% concentration) before and after use. Avoid reusing needles unless properly sterilized, as residual spores or contaminants can compromise your work. For alcohol sterilization, submerge the needle for 10–15 minutes, then allow it to air-dry in a sterile environment.
Handling Techniques: Always work in a clean, controlled space, ideally a still air box or laminar flow hood, to minimize airborne contaminants. Hold the syringe firmly but gently to avoid accidental needle pricks. When injecting spores into substrate jars or agar, insert the needle at a 45-degree angle to reduce damage to the substrate. After use, dispose of needles in a sharps container to prevent injuries and cross-contamination.
Personal Protective Equipment (PPE): Wear nitrile gloves to protect against skin contact with spores or chemicals. Safety goggles are essential to guard against accidental splashes or airborne particles. A lab coat or apron adds an extra layer of protection, particularly when working with multiple samples. PPE not only safeguards you but also maintains the integrity of your experiment by reducing human-borne contaminants.
Storage and Labeling: Store spore syringes and needles separately in a cool, dark place to preserve viability. Label all containers with the spore strain, date, and sterilization status to avoid confusion. Keep needles in their original packaging until ready for use, and ensure they are inaccessible to children or untrained individuals. Proper organization minimizes the risk of mishandling and ensures traceability in case of issues.
Emergency Preparedness: Accidental needle sticks can occur despite precautions. If a prick happens, wash the area with soap and water for at least 10 minutes, then apply an antiseptic. Seek medical attention if the needle was previously used by another person or if redness or swelling develops. Familiarize yourself with local biohazard disposal regulations to handle contaminated materials responsibly.
Preventing Spores: Effective Time and Temperature Control Strategies Explained
You may want to see also
Frequently asked questions
No, spore syringes typically do not come with needles. They usually include only the syringe filled with a spore solution and sometimes a sterile needle separately, depending on the vendor.
Yes, you can use a spore syringe without a needle by carefully dispensing the spore solution directly onto your substrate or medium, though a needle is often recommended for precision.
Needles for spore syringes can be purchased from the same vendor selling the syringes, online marketplaces, or local suppliers that carry laboratory or mycology equipment.
While not strictly necessary, needles are highly recommended for precise and sterile inoculation of substrates, ensuring better results in mushroom cultivation.